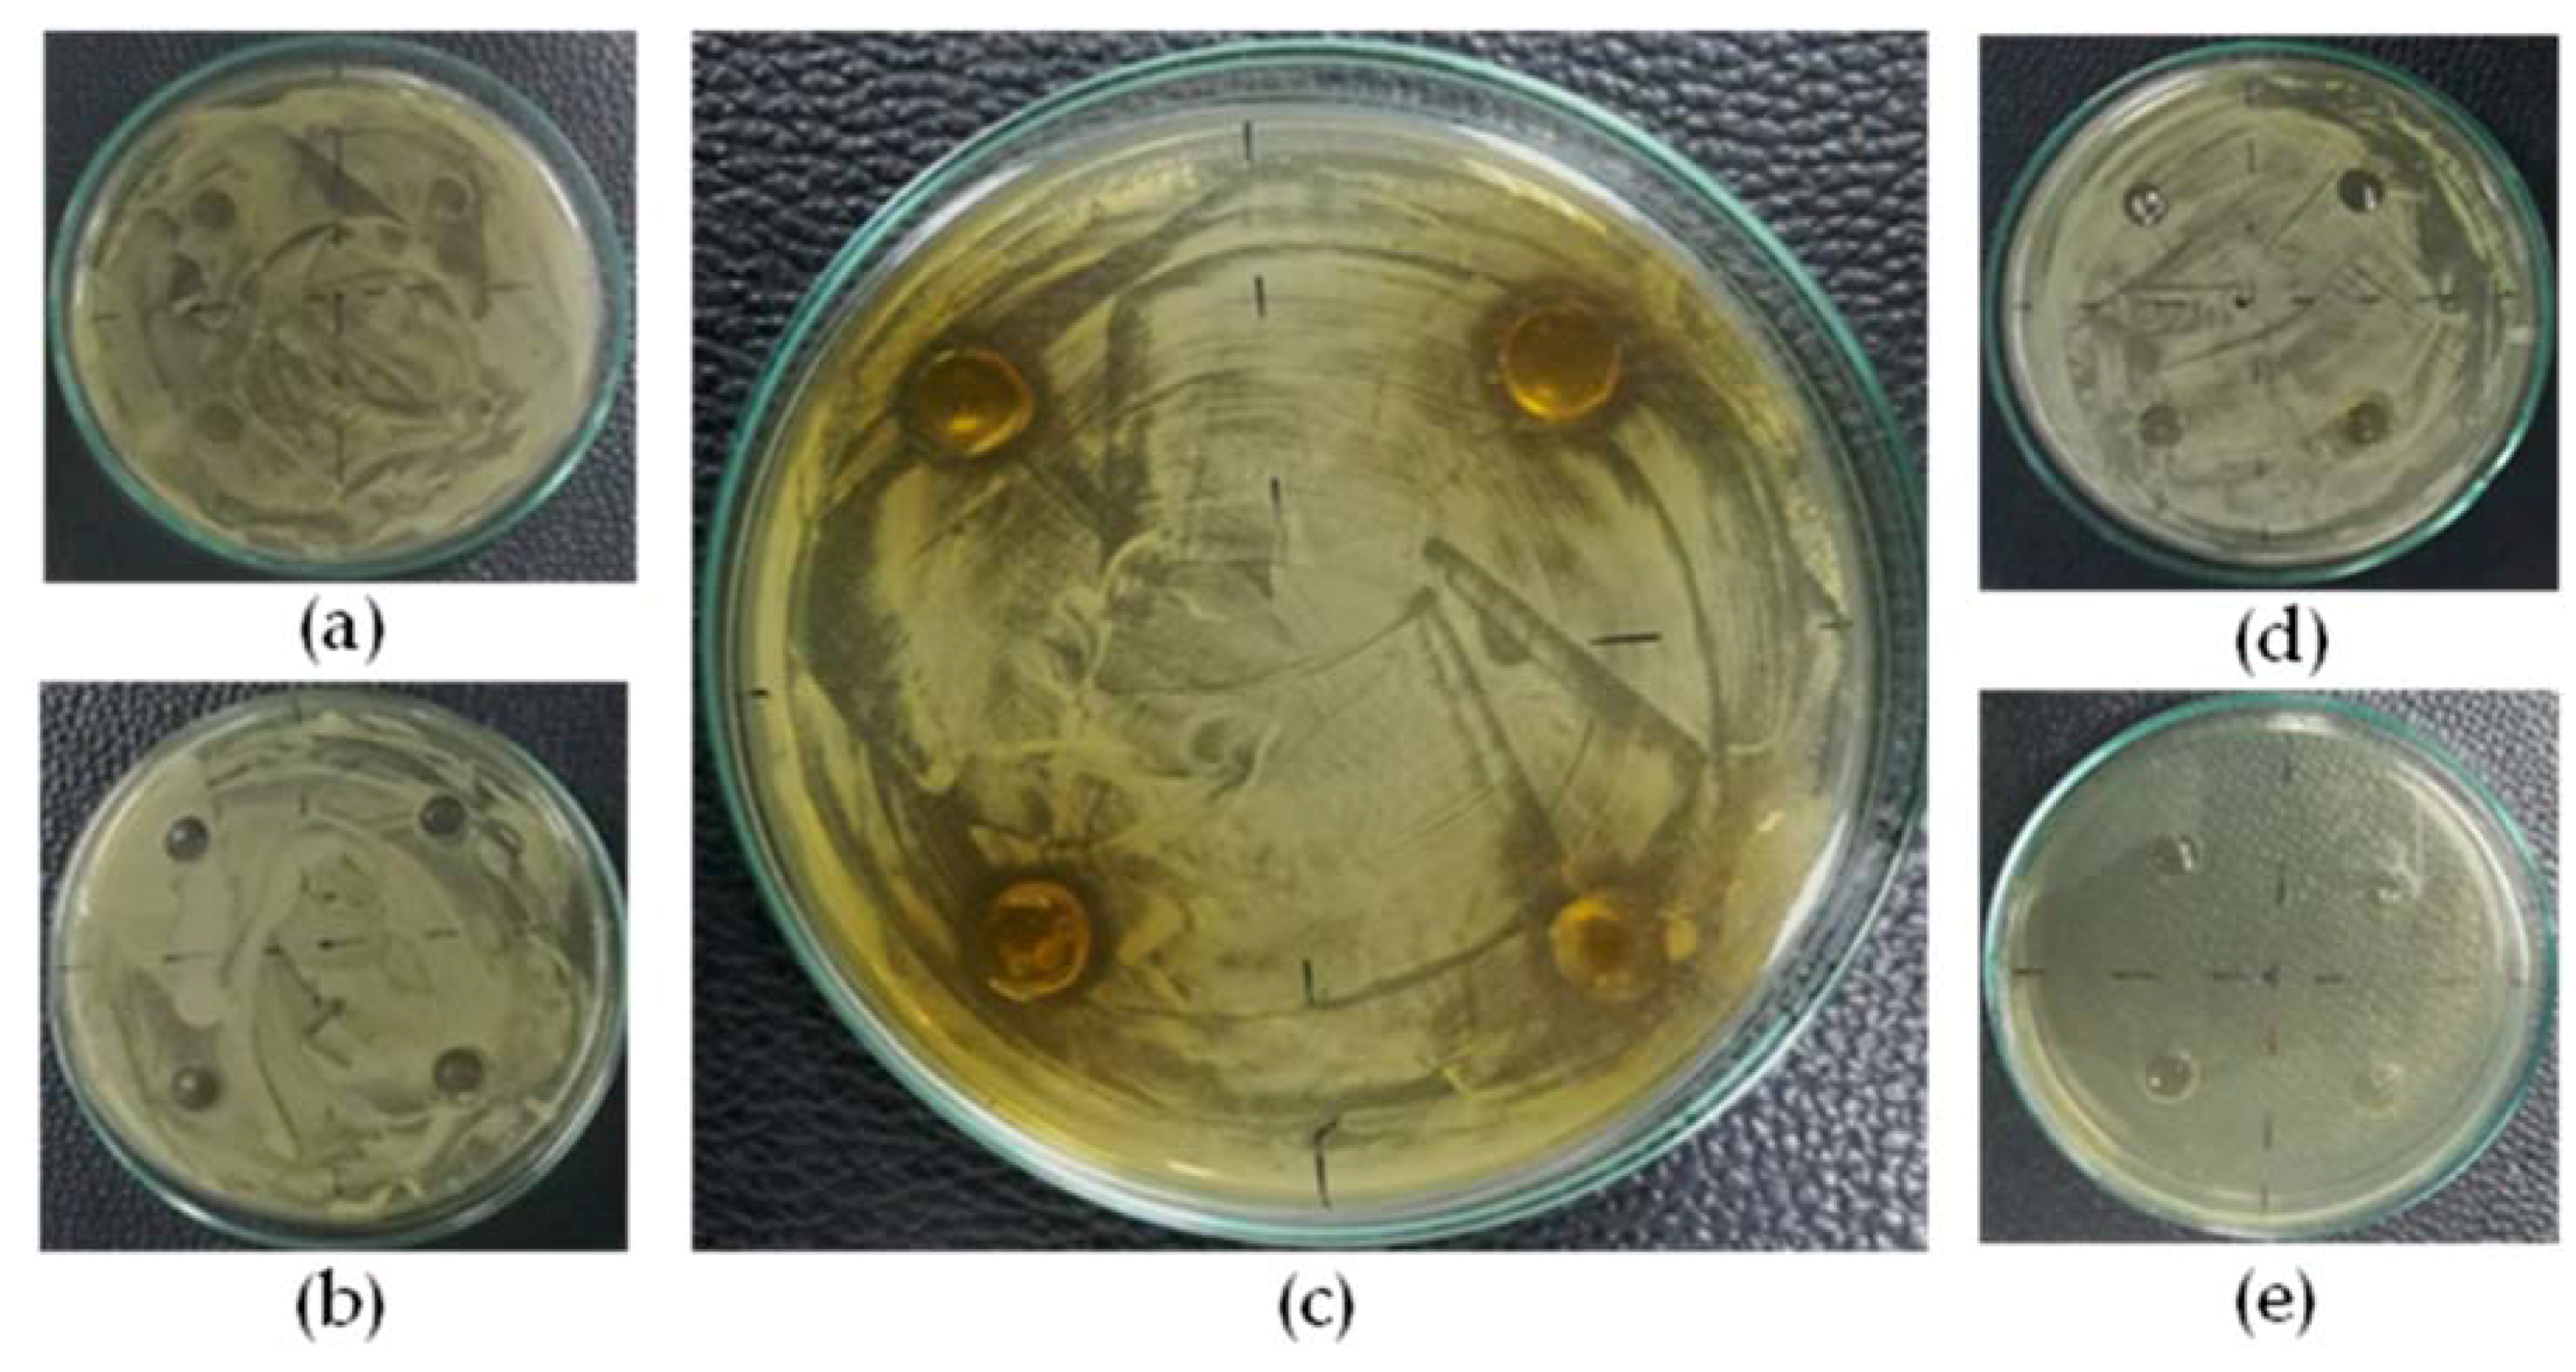
Scipharm 86 00008 g003

In Vitro Antimicrobial Activity of Gel Containing the Herbal Ball Extract against Propionibacterium acnes
Abstract
1. Introduction
2. Materials and Methods
2.1. Materials
2.2. Preparation of Herbal Ball and Herbal Ball Extract
2.3. Evaluation of Herbal Ball Extract
2.3.1. Antioxidant Activity
2.3.2. Anti Propionibacterium acnes Activity
2.4. Preparation of Gel Formulation Containing the Herbal Ball Extract
2.5. Evaluation of Gel Formulation Containing the Herbal Ball Extract
2.5.1. Physicochemical Properties
2.5.2. Anti Propionibacterium acnes Activity
2.5.3. Stability Study
3. Results and Discussion
3.1. Antioxidant Activity of the Herbal Ball Extract
3.2. Propionibacterium acnes Activity of Herbal Ball Extract
3.3. Physicochemical Properties of Gel Formulation Containing the Herbal Ball Extract and Stability
3.4. Anti Propionibacterium acnes Activity of Gel Formulation Containing the Herbal Ball Extract
4. Conclusions
Acknowledgments
Author Contributions
Conflicts of Interest
References
- Institute of Dermatology, Department of Medical Sciences, Ministry of Public Health, Thailand. Available online: http://inderm.go.th/inderm/inderm_pan.php (accessed on 4 January 2018).
- Zaenglein, A.L.; Pathy, A.L.; Schlosser, B.J.; Alikhan, A.; Baldwin, H.E.; Berson, D.S.; Bowe, W.P.; Graber, E.M.; Harper, J.C.; Kang, S.; et al. Guidelines of care for the management of acne vulgaris. J. Am. Acad. Dermatol. 2016, 74, 945–973. [Google Scholar] [CrossRef] [PubMed]
- Patel, M.; Bowe, W.P.; Heuqhebaert, C.; Shalita, A.R. The development of antimicrobial resistance due to the antibiotic treatment of acne vulgaris: A review. J. Drugs Dermatol. 2010, 9, 655–664. [Google Scholar] [PubMed]
- Chomnawang, M.T.; Surassmo, S.; Nukoolkarn, V.S.; Gritsanapan, W. Antimicrobial effects of Thai medicinal plants against acne-inducing bacteria. J. Ethnopharmacol. 2005, 101, 330–333. [Google Scholar] [CrossRef] [PubMed]
- Neamsuvan, O.; Kama, A.; Salaemae, A.; Leesen, S. A survey of herbal formulas for skin diseases from Thailand’s three southern border provinces. J. Herb. Med. 2015, 5, 190–198. [Google Scholar] [CrossRef]
- Azimi, H.; Fallah-Tafti, M.; Khakshur, A.A.; Abdollahi, M. A review of phytotherapy of acne vulgaris: Perspective of new pharmacological treatments. Fitoterapia 2012, 83, 1306–1317. [Google Scholar] [CrossRef] [PubMed]
- National List of Essential Medicines, 2018—Thailand. Available online: http://www.ratchakitcha.soc.go.th/DATA/PDF/2561/E/014/4.PDF (accessed on 19 February 2018).
- Juckmeta, T.; Thongdeeying, P.; Itharat, A. Inhibitory effect on β-hexosaminidase release from RBL-2H3 cells of extracts and some pure constituents of Benchalokawichian, a Thai herbal remedy, used for allergic disorders. Evid. Based Complement. Altern. Med. 2014, 2014, 828760. [Google Scholar] [CrossRef] [PubMed]
- Lertlop, W. The appropriate temperature of the Thai herbal ball compress for relaxing effected. Procedia Soc. Behav. Sci. 2015, 197, 1653–1660. [Google Scholar] [CrossRef][Green Version]
- Nuaeissara, S.; Kondo, S.; Itharat, A. Antimicrobial activity of the extracts from Benchalokawichian remedy and its components. J. Med. Assoc. Thai. 2011, 94 (Suppl. 7), S172–S177. [Google Scholar] [PubMed]
- Wangthong, S.; Palaga, T.; Rengpipat, S.; Wanichwecharungruang, S.P.; Chanchaisak, P.; Heinrich, M. Biological activities and safety of Thanaka (Hesperethusa crenulata) stem bark. J. Ethnopharmacol. 2010, 132, 466–472. [Google Scholar] [CrossRef] [PubMed]
- Sharma, R.; Kishore, N.; Hussein, A.; Lall, N. The potential of Leucosidea sericea against Propionibacterium acnes. Phytochem. Lett. 2014, 7, 124–129. [Google Scholar] [CrossRef]
- Chen, Z.; Bertin, R.; Froldi, G. EC50 estimation of antioxidant activity in DPPH· assay using several statistical programs. Food Chem. 2013, 138, 414–420. [Google Scholar] [CrossRef] [PubMed]
- Rao, P.R.; Rathod, V.K. Rapid extraction of andrographolide from Andrographis paniculata Nees by three phase partitioning and determination of its antioxidant activity. Biocatal. Agric. Biotechnol. 2015, 4, 586–593. [Google Scholar] [CrossRef]
- Anand, T.; Mahadeva, N.; Phani, K.G.; Farhath, K. Antioxidant and DNA damage preventive properties of Centella asiatica (L.) Urb. Phcog. J. 2010, 2, 53–58. [Google Scholar] [CrossRef]
- Kuete, V. Potential of Cameroonian plants and derived-products against microbial infections: A review. Planta Med. 2010, 76, 1479–1491. [Google Scholar] [CrossRef] [PubMed]
- Julianti, E.; Rajah, K.K.; Fidrianny, I. Antibacterial activity of ethanolic extract of cinnamon bark, honey and their combination effects against acne-causing bacteria. Sci. Pharm. 2017, 85, 19. [Google Scholar] [CrossRef] [PubMed]
- Singha, P.K.; Roy, S.; Dey, S. Antimicrobial activity of Andrographis paniculata. Fitoterapia 2003, 74, 692–694. [Google Scholar] [CrossRef]
- Arifullah, M.; Namsa, N.D.; Mandal, M.; Chiruvella, K.K.; Vikrama, P.; Gopal, G.R. Evaluation of anti-bacterial and anti-oxidant potential of andrographolide and echiodinin isolated from callus culture of Andrographis paniculata Nees. Asian Pac. J. Trop. Biomed. 2013, 3, 609–610. [Google Scholar] [CrossRef]
- Islam, M.T.; Rodriquez-Hornedo, N.; Ciotti, S.; Ackermann, C. Rheological characterization of topical carbomer gels neutralized to different pH. Pharm. Res. 2004, 21, 1192–1199. [Google Scholar] [CrossRef] [PubMed]
- Lambers, H.; Piessens, S.; Bloem, A.; Pronk, H.; Finkel, P. Natural skin surface pH is on average below 5, which is beneficial for its resident flora. Int. J. Cosmet. Sci. 2006, 28, 359–370. [Google Scholar] [CrossRef] [PubMed]

| Properties | Formulations | ||
|---|---|---|---|
| 0.1% w/w | 1% w/w | 5% w/w | |
| Appearance | ![]() | ![]() | ![]() |
| Color | Pale yellow | Yellow-brown | Dark brown |
| Odor | - | - | Mild odor |
| Homogeneity | +++ | +++ | +++ |
| pH | 5.58 ± 0.02 | 6.61 ± 0.02 | 7.24 ± 0.01 |
© 2018 by the authors. Licensee MDPI, Basel, Switzerland. This article is an open access article distributed under the terms and conditions of the Creative Commons Attribution (CC BY) license (http://creativecommons.org/licenses/by/4.0/).
Share and Cite
Jantarat, C.; Sirathanarun, P.; Chuchue, T.; Konpian, A.; Sukkua, G.; Wongprasert, P. In Vitro Antimicrobial Activity of Gel Containing the Herbal Ball Extract against Propionibacterium acnes. Sci. Pharm. 2018, 86, 8. https://doi.org/10.3390/scipharm86010008
Jantarat C, Sirathanarun P, Chuchue T, Konpian A, Sukkua G, Wongprasert P. In Vitro Antimicrobial Activity of Gel Containing the Herbal Ball Extract against Propionibacterium acnes. Scientia Pharmaceutica. 2018; 86(1):8. https://doi.org/10.3390/scipharm86010008
Chicago/Turabian StyleJantarat, Chutima, Pornpak Sirathanarun, Tatsanee Chuchue, Atthaphon Konpian, Gorawit Sukkua, and Prutthicha Wongprasert. 2018. "In Vitro Antimicrobial Activity of Gel Containing the Herbal Ball Extract against Propionibacterium acnes" Scientia Pharmaceutica 86, no. 1: 8. https://doi.org/10.3390/scipharm86010008
APA StyleJantarat, C., Sirathanarun, P., Chuchue, T., Konpian, A., Sukkua, G., & Wongprasert, P. (2018). In Vitro Antimicrobial Activity of Gel Containing the Herbal Ball Extract against Propionibacterium acnes. Scientia Pharmaceutica, 86(1), 8. https://doi.org/10.3390/scipharm86010008



